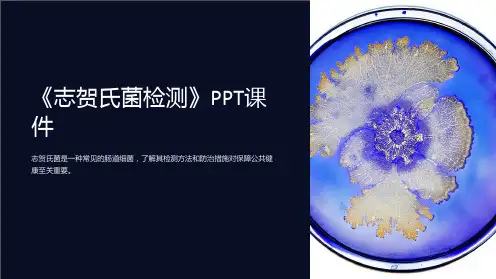

志贺氏菌的检验讲解
- 格式:ppt
- 大小:1.46 MB
- 文档页数:37

志贺氏菌的鉴定要点志贺氏菌(Salmonella typhi)是引起伤寒病的致病菌,其鉴定对于诊断和防控伤寒病具有重要意义。
下面我们将从菌落特征、生物化学反应、免疫学方法等几个方面介绍志贺氏菌的鉴定要点。
一、菌落特征志贺氏菌的菌落形态多样,但一般具有以下特征:1. 形态:菌落呈圆形或不规则形状,边缘整齐或呈波浪状。
2. 颜色:菌落表面呈乳白色、灰白色或淡黄色。
3. 粘液性:菌落表面有时出现透明的粘液层。
4. 反射性:菌落表面有时呈金属光泽。
5. 直径:菌落直径一般为2-3毫米,但也有较大的菌落。
二、生物化学反应志贺氏菌的生物化学反应是鉴定的重要依据之一,常用的方法包括氧化/发酵反应、代谢产物反应、酶反应等。
1. 氧化/发酵反应:志贺氏菌能利用葡萄糖产生酸和气体,而不能利用乳糖产生酸和气体,这是其与大肠杆菌等其他肠道细菌的区别之一。
2. 代谢产物反应:志贺氏菌在代谢过程中产生一些特殊的代谢产物,如硫化氢和尿素酶等。
3. 酶反应:志贺氏菌具有一些特定的酶活性,如葡萄糖酶、麦芽糖酶和内切酶等。
三、免疫学方法免疫学方法是志贺氏菌鉴定的重要手段,包括血清学方法和分子生物学方法。
1. 血清学方法:通过检测志贺氏菌特异性抗原和抗体的反应来鉴定菌株。
常用的方法有血清凝集试验、血清中和试验和酶联免疫吸附试验等。
2. 分子生物学方法:利用PCR技术检测志贺氏菌的特异性基因序列,如vi抗原基因和fliC基因等。
除了上述的菌落特征、生物化学反应和免疫学方法,还有一些其他的鉴定要点需要注意:1. 样品的处理:鉴定志贺氏菌需要注意样品的采集和保存,避免污染和细菌数量的剧烈变化。
2. 培养基的选择:选择适宜的培养基,如MacConkey琼脂和XLD琼脂等,以利于志贺氏菌的生长和鉴定。
3. 防止交叉反应:志贺氏菌与其他细菌在某些生物化学反应上存在交叉反应,需要进行鉴别。
4. 结合多种方法:综合应用不同的鉴定方法可以提高鉴定的准确性和可靠性。

•志贺氏菌简介•志贺氏菌的检验方法•志贺氏菌检验的实验室要求•志贺氏菌检验的临床意义•志贺氏菌检验的未来发展方向•志贺氏菌检验方法的研究进展•志贺氏菌检验方法在公共卫生领域的应用目录革兰阴性杆菌需氧菌致病性菌030201志贺氏菌的特性03传播方式01引发痢疾02毒素作用志贺氏菌的致病性食物污染水源污染直接接触志贺氏菌的传播途径分离培养通过形态学、生化反应等方式对分离得到的菌株进行鉴定。
鉴定耐药性检测细菌培养法免疫印迹法免疫荧光法血清学检测免疫学方法1 2 3PCR技术基因测序基于质谱的技术分子生物学方法实验室应具备有效的通风系统,以减少空气中细菌的数量。
实验室应设有独立的微生物培养室,以防止细菌的交叉污染。
实验室应配备高级别的个人防护装备,如实验室大褂、口罩、手套、护目镜等。
实验室设施与安全实验器材的清洁与消毒所有用于细菌培养的器材,如培养皿、试管、移液管等,应在使用后立即清洗并消毒。
实验用具如显微镜、放大镜等,应定期进行擦拭和清洁。
实验操作规范与安全防护措施01020304通过对志贺氏菌的检验,可以了解疾病在人群中的流行情况,为制定防控措施提供依据。
诊断感染性疾病流行病学调查志贺氏菌感染药敏试验耐药性监测指导抗菌药物使用疫情预警通过对志贺氏菌的监测,可以及时发现疫情,为采取防控措施提供时间保障,从而控制疾病的传播。
流行趋势分析通过对不同地区、不同时间的志贺氏菌检测数据进行分析,可以了解疾病在时间和空间上的变化趋势,为制定疾病防控策略提供依据。
监测疾病流行趋势基于生物信息学的方法基于免疫学的方法基于纳米技术的检测方法新技术的开发与应用基于微流控技术的检测设备基于机器学习的智能检测设备自动化与智能化检测设备的应用提高检测灵敏度和特异性等方面的研究进展开发新的信号放大技术研究新的核酸提取和纯化方法基因组学研究进展基因组学研究进化分析功能基因组学研究研究志贺氏菌感染后机体的免疫应答机制,包括抗体、细胞因子、固有免疫细胞等在抵抗感染中的作用,为开发新型疫苗和治疗药物提供理论支持。
01 Chapter志贺氏菌的特性030201志贺氏菌的致病性引发痢疾志贺氏菌具有较强的传染性,主要通过粪-口途径传播。
传染性强耐药性增强志贺氏菌的传播途径02 Chapter鉴定通过观察细菌的形态、染色特性、生化反应等指标,对分离出的细菌进行鉴定。
分离培养通过采集患者的粪便、尿液、血液等样本进行培养,以分离出志贺氏菌。
药敏试验对分离出的志贺氏菌进行药敏试验,以确定其对抗菌药物的敏感性。
细菌培养法酶联免疫吸附试验(ELISA)免疫荧光抗体技术免疫学检测法聚合酶链式反应(PCR)通过扩增志贺氏菌的基因片段,以检测患者样本中的志贺氏菌。
基因测序对志贺氏菌的基因进行测序,以鉴定其种型和耐药性。
分子生物学检测法03 Chapter粪便样品采集食品样品采集采集对象为可疑污染食品,包括肉类、蔬菜、水果等。
采集方法为选取可疑污染食品,按照食品采样标准进行采集,并尽快送检。
食品样品是志贺氏菌检验的重要来源之一。
水质样品采集04 Chapter样品处理增菌培养样品处理与增菌培养分离培养与生化鉴定分离培养将增菌培养后的样品进行分离培养,以获得单个菌落。
生化鉴定对分离培养得到的菌落进行生化鉴定,包括糖发酵试验、柠檬酸盐利用试验、吲哚试验等,以确定是否为志贺氏菌。
血清学分型与药敏试验血清学分型药敏试验05 Chapter01020304使用无菌容器收集样品,避免容器被污染。
采集容器遵循无菌操作原则,避免样品受到外界污染。
采集方法采集足够量的样品,以便进行后续实验分析。
采集量尽量在发病初期或发病高峰期采集样品,以提高检出率。
采集时间样品采集前的注意事项实验室操作的注意事项实验室环境实验器材实验操作实验试剂检验结果的分析与解读01020304检验结果结果解读结果分析结果报告06 Chapter提高检测灵敏度的方法改进采用先进的扩增技术选择特异性更高的抗体增加样品前处理快速检测技术的研发与应用基于分子生物学技术的其他检测方法探索基于下一代测序技术的检测基于生物信息学的检测THANKS。